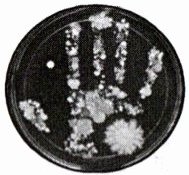

20. 国家一级保护动物——麝(shè),因李时珍说其香气能向远处播散而得名,它属于食草类哺乳动物。如图是麝和哺乳动物牙齿的结构模式图,以下说法错误的是(

A.麝具有胎生哺乳的特征,胎生哺乳能提高后代的成活率
B.麝体温恒定,体温恒定是哺乳动物特有的特征
C.麝体表被毛,有发达的神经系统和感觉器官
D.麝的牙齿有分化,图甲是麝的牙齿
B
)A.麝具有胎生哺乳的特征,胎生哺乳能提高后代的成活率
B.麝体温恒定,体温恒定是哺乳动物特有的特征
C.麝体表被毛,有发达的神经系统和感觉器官
D.麝的牙齿有分化,图甲是麝的牙齿
答案:
20. B
21. 人们常说“菌从手来,病从口入”。人的手上有大量微生物,无菌固体培养基经人手按压,培养一段时间后呈现如图所示的结果。下列相关叙述不正确的是(
A.培养基上生长的菌落形态、大小不同
B.手上可能既有细菌又有真菌
C.用清水洗手可起到灭菌作用
D.手上的微生物不一定都对人体有害
C
)A.培养基上生长的菌落形态、大小不同
B.手上可能既有细菌又有真菌
C.用清水洗手可起到灭菌作用
D.手上的微生物不一定都对人体有害
答案:
21. C
22. 右图为巴斯德的“鹅颈瓶”实验,对该实验分析不正确的是(

A.弯曲细长的玻璃管阻碍了空气的进入
B.肉汤煮沸的目的是杀死瓶内的微生物
C.细菌进入肉汤通过分裂的方式快速繁殖
D.实验结果说明生命不能从非生命产生
A
)A.弯曲细长的玻璃管阻碍了空气的进入
B.肉汤煮沸的目的是杀死瓶内的微生物
C.细菌进入肉汤通过分裂的方式快速繁殖
D.实验结果说明生命不能从非生命产生
答案:
22. A
23. 生物兴趣小组举行蘑菇种植比赛,他们发现菌棒“变白”后会长出蘑菇,以下说法或做法不合理的是(

A.蘑菇属于大型真菌
B.菌棒内接种了蘑菇的孢子
C.菌棒内部“变白”是菌丝生长的表现
D.蘑菇的营养菌丝吸收水和无机盐,能自养
D
)A.蘑菇属于大型真菌
B.菌棒内接种了蘑菇的孢子
C.菌棒内部“变白”是菌丝生长的表现
D.蘑菇的营养菌丝吸收水和无机盐,能自养
答案:
23. D
查看更多完整答案,请扫码查看